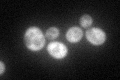
YLR384C
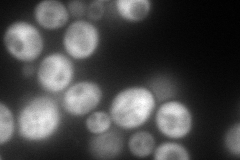
YLR384C
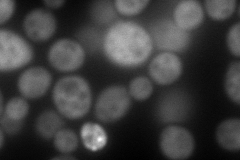
YLR384C
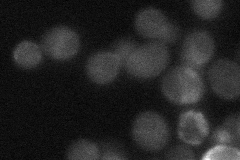
YLR384C
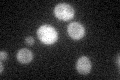
YLR384C

View description
Subunit of Elongator complex, which is required for modification of wobble nucleosides in tRNA; maintains structural integrity of Elongator; homolog of human IKAP, mutations in which cause familial dysautonomia (FD)
Localization:
Intensity:
Fold change:
Significance:
-
C’ GFP library in SD
cytosol67.87 -
N' NOP1pr-GFP in SD
cytosol313.115 -
N' TEF2pr-mCherry in SD
cytosol200.95 -
N' NATIVEpr-GFP in SD
below threshold24.1108 -
N' TEF2pr-VC and Cyto-VN in SD

#N/A0 -
C’ GFP library in SD+DTT

cytosol58.890.86No -
C’ GFP library in SD+H2O2

punctate, cytosolN/AN/ANo -
C’ GFP library in Starvation Media
cytosol37.60.55No -
C’ GFP library on the background of Pup2-DaMP

cytosol -
C’ GFP library on the background of CCT mutant

cytosol83.90481.2361No
